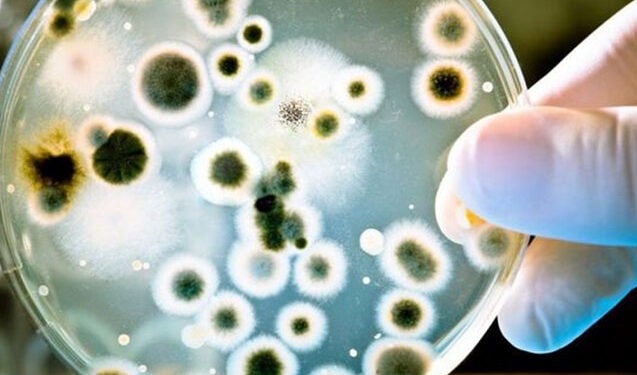
Bədənimizdəki bu nahiyələr mikrobla dolu imiş – Diqqət!

Alimlər insan bədəninin daha mikroblu nahiyələrini aşkar ediblər.
“Obyektivtv.az” xəbər verir ki, bu barədə “Daily Mail” yazıb.
Bununla bağlı Vaşinqton Universitetinin alimləri araşdırma aparıblar. Professor Crandallın rəhbərliyi altında tədqiqat işində 129 magistr və bakalavr tələbəsi iştirak edib.
Məlum olub ki, qulaqların, ayaq barmaqlarının arxası və qarın nahiyəsi (göbək hissə) mikrobların yaşayıb çoxalması üçün ən qaynar nöqtələrdir. Çünki bu hissələr çox vaxt daha nəmli və isti olur. Bu da bakteriyaların inkişafı üçün mükəmməl şərait yaradır.
Professor Crandall bildirib ki, burada artan mikroblar ekzema və ya sızanaq kimi dəri xəstəliklərinə səbəb ola bilər. Onun sözlərinə görə, həmin nahiyələr hərtərəfli və tez-tez təmizlənərsə, bunun qarşısını almaq olar.